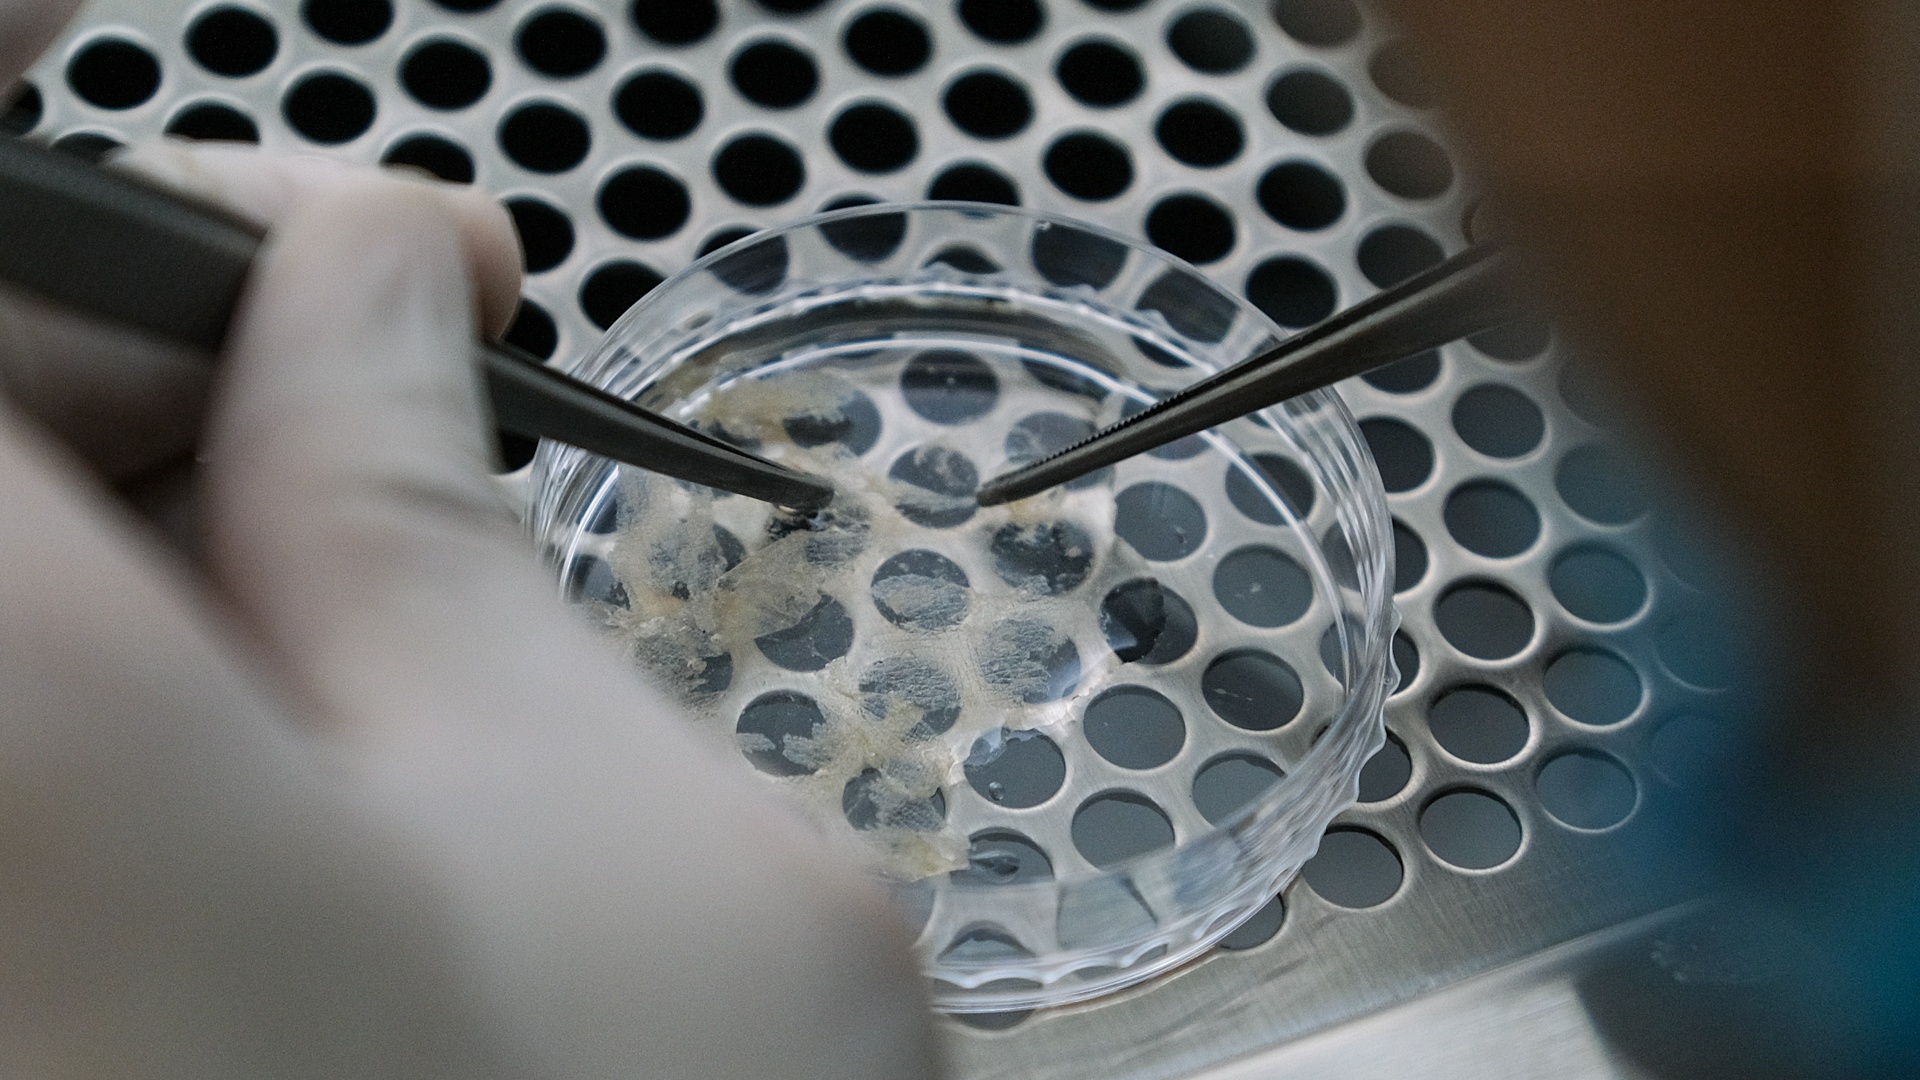

|
| Tôi là Nguyễn Hồng Hạnh, sống tại Lào Cai. Tôi là bệnh nhân bạch biến suốt 26 năm nay. Căn bệnh từng khiến tôi đau đớn, ám ảnh khi trở thành học sinh cá biệt. 6h sáng 5/6, tôi và cha mẹ đã có mặt tại Bệnh viện Da liễu Trung ương để chuẩn bị cho ca ghép tế bào thượng bì tự thân không qua nuôi cấy để chữa căn bệnh này. |
 |
| Cha mẹ tôi đã rất vất vả chạy theo tất cả biện pháp để những vết loang lổ kia biến mất nhưng không thành. Hôm nay, tôi có niềm tin ca ghép tế bào gốc sẽ thành công. Và giấc mơ của tôi sẽ thành sự thực. |
 |
| Cả đêm hôm trước mẹ tôi không ngủ được. Bà ôm tôi và không ngừng rơi nước mắt như từng làm suốt 26 năm qua. |
 |
| Gần 8h, tôi bước vào phòng phẫu thuật. Bước đầu tiên, bác sĩ dùng thiết bị chuyên dụng để định hình tổn thương do bạch biến trên khuôn mặt tôi. |
 |
| Bản chất bệnh bạch biến là da vùng bị bệnh mất đi sắc tố melanin, chỉ còn lại màu trắng. Bác sĩ đã cắt một phần tóc của tôi để lộ vết bạch biến trước khi thực hiện các bước tiếp theo. Tôi khá bất ngờ nhưng chỉ một thoáng sau, tôi kịp lấy lại bình tĩnh. Không sao, chúng sẽ mọc lại. |
 |
| Ngay sau đó, tôi được ê-kíp bác sĩ thông báo chuẩn bị gây mê. Tôi khá sợ. Thấy vậy, các bác sĩ giúp tôi thả lỏng bằng cách nói chuyện, hỏi han, thậm chí trêu đùa... “Sao em không biết gì thế này” - tôi chỉ kịp thốt nhẹ rồi chính thức mê man trong khoảng một tiếng. |
 |
| Lúc này, ThS.BS Hoàng Văn Tâm - Phó trưởng Khoa Điều trị nội trú ban ngày - sẽ tiến hành lấy da ở mặt trước đùi của tôi. Đối với tôi, anh không chỉ là bác sĩ mà còn là một người anh, một ân nhân. “Em gái ơi, giấc mơ của em sắp thành hiện thực rồi” - anh nhắn cho tôi thời điểm trước Tết. |
 |
| Bác sĩ Tâm dùng tay để lấy da thay vì máy. Nhờ đó, bác sĩ sẽ kiểm soát được độ mỏng tốt hơn, tránh cho tôi vết sẹo ở đùi. |
 |
| Sau đó, những miếng da này sẽ được đưa vào trong dung dịch, qua các công đoạn sẽ tách lấy tế bào thượng bì, nuôi dưỡng, đếm tế bào trước khi ghép vào vùng da bị bạch biến. |
 |
| Vùng da bị bệnh được bào mòn bằng laser để sẵn sàng ghép tế bào gốc. Điều gây ảnh hưởng lớn và khủng khiếp nhất đối với người bệnh bạch biến là sự tự ti. Đa phần cảm xúc đó xuất phát từ sự kỳ thị của những người xung quanh. |
|
| Tôi đã trải qua những tháng ngày đó. Tôi học trang điểm, cố tìm cách che đi vết trắng loang lổ trên khuôn mặt. Sau tất cả, tôi là một người may mắn khi đã tự tin bước tiếp, chấp nhận bản thân. Nhưng không phải bệnh nhân bạch biến nào cũng làm được như vậy. |
 |
| Bước ghép tế bào gốc trực tiếp lên vết bạch biến được thực hiện khi tôi đã tỉnh. Sau khi thoát mê, tôi có mê sảng một chút và được nói chuyện với ê-kíp. Không khí trong phòng phẫu thuật thực sự thân thiện, vui vẻ, khác những gì tôi đã tưởng tượng. |
 |
| Tế bào ghép vào sẽ được dùng gạc cố định lại và tháo ra trong vòng một tuần. Gần 12h, tôi được đưa ra ngoài, nơi cha mẹ đang hồi hộp chờ đợi. Ca ghép tế bào diễn ra khá nhẹ nhàng. Tôi có thể trở về nhà ngay, không cần nằm viện. Kết quả sẽ được ghi nhận trong vài tuần tới. |
 |
| Nếu thành công với phương pháp này, các vết bạch biến sẽ biến mất vĩnh viễn, tôi sẽ có một khuôn mặt bình thường như bất cứ ai. |
 |
| Sau ca ghép tế bào thượng bì tự thân không qua nuôi cấy, tôi trở về Lào Cai nghỉ ngơi. Hàng ngày, tôi thay băng theo hướng dẫn của bác sĩ và vẫn sinh hoạt bình thường. Hôm nay (20/6), sau hai tuần, tôi xuống Hà Nội gặp bác sĩ Tâm để tái khám. |
 |
| Bác sĩ cho biết kết quả ca ghép của tôi rất tốt. Vùng bạch biến của tôi đã xuất hiện các đốm đen và tiếp tục tiến triển. Anh bảo sau vài tháng tới, tôi sẽ có diện mạo mới. Tôi rất hạnh phúc. |
 |
| Ngày hôm sau, tôi tham dự Lễ kỷ niệm Ngày bạch biến thế giới được tổ chức tại Bệnh viện Da liễu Trung ương. Tiếp xúc và lắng nghe nhiều tâm sự của người đồng bệnh, tôi rất thương họ. Những vết trắng loang lổ đeo bám cuộc đời họ mang theo nhiều đau khổ. |
  |
| Nếu giấc mơ thành sự thật, tôi sẽ rất hạnh phúc bởi không chỉ mình, những người bệnh khác cũng tìm thấy niềm hy vọng. Bác sĩ Hoàng Văn Tâm cũng vậy, bởi nhiều năm trăn trở cùng bệnh nhân bạch biến, giấc mơ của anh chính là chữa được bệnh cho chúng tôi. |



